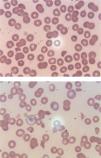
fig0002

The messenger RNA-1273 vaccine, known as the Moderna COVID 19 Vaccine, was the second FDA-authorized vaccine during COVID-19 Pandemic.1 The mRNA vaccine encodes the spike protein of SARS-CoV-2 which results in antibody mediated immune response. The safety and efficacy of these vaccines continues to be studied with multiple unidentified factors influencing their tolerability. Few case series have reported secondary immune thrombocytopenia (ITP) occurring following administration of the mRNA COVID 19 vaccines.2 Herein, we present a case of acquired thrombotic thrombocytopenic purpura (TTP) through ADAMTS13 autoimmune antibody following administration of two doses of the Moderna COVID 19 vaccine, resulting in a fatal outcome.
The case presentationA 58-year-old white male with a history of hypertension, morbid obesity, and human immunodeficiency virus (HIV) infection on HAART (highly active antiretroviral therapy), was sent to the emergency room (ER) by his primary care physician (PMD) for platelet count of 12×10^3/mm3. The patient was complaining of significant fatigue, non-traumatic bruises on his right arm, and persistent dark colored urine which prompted his visit to his PMD. He denied any other active muco-cutaneous bleeding or lesions, headache, confusion, dizziness, recent nausea, vomiting, diarrhea, upper or lower respiratory symptoms, or neurological deficits. The patient is compliant with his medications of dolutegravir, lopinavir and ritonavir for his HIV infection and his CD4 count has been stable (Table 1). He denied any recent changes in his medications, recent antibiotic, or herbal supplements use. He received the first dose of the Moderna mRNA COVID vaccine 6 weeks prior to presentation, followed by the second dose of the same vaccine in his left deltoid 3 weeks later without any major or minor complications. Although his precise platelet count when he received the first and second doses of the vaccine is unknown, the patient's average platelet count (PLT) was stable three months before presentation (Table 1).
Laboratory results of our patient.
Abbreviation: WBCs (white cell count); RBCs (red blood cell count); MCV (mean corpuscular volume); RDW (Red Cell Distribution Width); RRC (Relative reticulocyte count); Cr (Creatinine); BUN (blood urea nitrogen); AST (aspartate aminotransferase); ALT (Alanine Aminotransferase); LDH (Lactate Dehydrogenase); CK (Creatine Kinase); PT (prothrombin time); INR (international normalized ratio); PTT (Partial thromboplastin time); HIV (human immunodeficiency virus); PCR (Polymerase chain reaction); HCV (Hepatitis C virus); Ab(Antibodies); HBV (Hepatitis B virus); HAV (Hepatitis A virus); CMV(Cytomegalovirus); IgG (Immunoglobulin G); EBV(Epstein-Barr virus); Crypto (Cryptococcal); Ag (antigen); RSV (Respiratory Syncytial Virus); MRSA (Methicillin-resistant Staphylococcus aureus); ANA(antinuclear antibodies); DS (double stranded); CCP (Cyclic Citrullinated Peptide); IgA (Immunoglobulin A); SCL-70(Scleroderma);
In the ER, he was Afebrile, and hemodynamically stable. His physical examination was unremarkable except for non-painful ecchymosis in the antecubital fossa of his right arm (Figure 1). Admission labs were significant for normocytic anemia with marked thrombocytopenia and elevated absolute reticulocyte count indicating adequate bone marrow response. He also had acute kidney injury and hematuria. His peripheral smear demonstrated schistocytes (>2-3/HPF) (Figure 2A,B). Further laboratory results were suggestive for microangiopathic hemolytic anemia (MAHA) with negative direct Coombs test and disseminated intravascular coagulopathy (DIC). No evidence of acute infection was noted clinically or on laboratory testing. Viral/bacterial studies were negative. He had undetectable HIV viral load with stable, high CD4 to CD8 ratio (Table 1).
A. Peripheral smear on initial presentation. B. Peripheral smear within hours later from presentation.
This peripheral smear is revealing thrombocytopenia, decreased lymphocytes, few schistocytes, target cells, few reticulocytes. This peripheral smear is revealing markedly abnormal cells including thrombocytopenia, lymphopenia, target cells, and abundant schistocytes. Technical aspect: Peripheral smear reviewed using Microscope Olympus BX45, 100x (oil) * ten magnification used, Leica microsystems software used to acquire images.
Given his high PLASMC score of 6, thrombotic thrombocytopenic purpura (TTP) was considered the working diagnosis (Table 2). The Patient was started on temporary resuscitation measures while preparing for therapeutic plasma exchange (TPE). He received two units of plasma (approximately 10 to 15 mL/kg), in addition to Dexamethasone 10 mg intravenously twice daily, and planned to transition to methylprednisolone 80 mg IV q8h in the following day. He was also initiated on mechanical venous thromboembolism prophylaxis given his severe thrombocytopenia and the active bleeding.
PLASMIC score system for Thrombotic Thrombocytopenic Purpura (TTP)4.
6 points indicating High risk group with 72 % Risk of severe ADAMTS13 deficiency (defined as ADAMTS13 activity level <15%)
Further laboratories had definitely ruled out an active source of infection, or underlying Systemic auto-immune diseases (SAID). Computed tomography scans of the head, chest, abdomen and pelvis were done to rule out any possibility of active internal bleeding and/or any source of infection. Finally, ADAMTS13 activity was reported to be low, with positive elevated ADAMTS13 antibodies which confirmed our diagnosis (Table 1). Unfortunately, within the subsequent 12 hours before initiating TPE, the patient quickly decompensated with rapidly rising troponin-I, and developed altered mental status, and respiratory failure. Eventually, he went into ventricular fibrillation and cardiac arrest. Full resuscitative measures were implemented with no return of spontaneous circulation. No autopsy was performed on the patient.
DiscussionTTP is a form of Thrombotic microangiopathy (TMA) caused by a deficiency or dysfunction of ADAMTS13, a circulating metalloprotease, leading to dysregulation of von Willebrand Factor (VWF) activity resulting in intravascular hemolysis and microvascular thrombi.3 There are two types of TTP; congenital and acquired. Acquired TTP is more common in African Americans, around the fourth decade of life, with a female to male ratio of 2-3:1.3 Acquired secondary TTP accounts for 69% of the cases where a known precipitating factor causes an autoimmune reaction and development of autoantibodies against the ADAMTS13 enzyme.3
Neurological deficits are common on presentation in 40% to 80% of cases followed by abnormal bleeding (46% of patients).3 Our patient represented the minority of the affected population being male, caucasion, and without any major or minor neurological symptoms. None of the known precipitating factors had been identified to explain such a disease in our case. Given the high mortality rates of TTP with delayed adequate treatment, the criteria for presumptive diagnosis only rely on thrombocytopenia with active hemolysis, in the absence of an obvious alternative cause, as in our case.3
Although multiple steps should be processed to confirm the diagnosis of TTP, Studies indicated that a plasma ADAMTS13 activity of <5–10% is highly specific for diagnosis.3 However, due to its high turnover time to obtain results, it was necessary to review the side effects of our patient's medications, and laboratory values to rule out other possible TMA causes, and any known precipitating factors for TTP, as well as initiate the appropriate treatment. According to Studies an alternative cause of TMA would be suggestive if the patient has PLT count >30 K/mm3, or has severe renal dysfunction.4 Our patient`s PLT, Creatinine (Cr) level, His PLASMIC score of 6, were within the range predicted for TTP in most studies.4 Although no autoantibodies to CFH (complement factor H) were obtained, which represent a significant etiology of atypical hemolytic uremic syndrome (aHUS) such as Shiga toxin, HUS and complement-mediated TMA, our patient did not complain of diarrheal disease.4
In terms of pathophysiology of the TTP, as in our case, early studies indicated high ADAMTS13 inhibitor autoantibodies are very specific for acquired TTP.3 After COVID-19 pandemic, many case series and studies showed that COVID-19 infection has its own risks for triggering such a disease. Although the exact pathophysiology is still in question, one theory suggests it`s secondary to immune complex mediated, and/ or direct cytokine mediated endothelial injury.5 Unfortunately, COVID-19 Antibody was not tested in our patient; however, his covid-SARS PCR was negative at presentation, and he didn't have any recognized past covid-19 infection. Furthermore, Patients with HIV are known to be at an increased risk for the development of TTP, particularly those with advanced disease and a low CD4 count.6 Despite its increased occurrence in this at-risk disease group, the prevalence decreased in the HAART (Highly active Anti-Retroviral Therapy.6 This patient's HIV was in remission with stable CD4 counts checked twice a year for the past 5-6 years. As per his primary doctor, he had no prior history of TTP, was compliant with ART with the same drug regimen over the last 5 years, and his last CD4 count was 506, three months before vaccination. The HIV viral load for the patient was also undetectable both before and during hospitalization. All these reasons were to question the role of the vaccine as a triggering factor.
The main risk of Autoimmune syndromes secondary to vaccines have been well documented in the past, some involving reactions secondary to H1N1, HBV, and HPV vaccines.7 These autoimmune responses are likely secondary to a molecular mimicry process, in which the immune system is introduced to certain pathogenic elements contained in the vaccine, which are very similar in structure to specific human proteins.7 This structural similarity causes the development of autoantibodies against human proteins, thus provoking an autoimmune response such as ITP.2 Recent studies reported that messenger RNA (mRNA)–based vaccines produced by Moderna (mRNA-1273) and Pfizer–BioNTech (BNT162b2) have been accompanied by Thrombocytopenia with concurrent major hemorrhage, with a similar mechanism of ITP, and no difference in incidence rate of cases between both types of vaccines has been documented.2,3 In contrast, ChAdOx1 nCoV-19 (AstraZeneca), a recombinant chimpanzee adenoviral vector encoding the spike protein of SARS-CoV-2, has been accompanied by thrombocytopenia with major thrombosis of abnormal places, an autoimmune reaction called vaccine-induced TTP which develops 5 to 24 days after initial dose.8 Due to its rarity, the precise pathophysiology of Covid vaccine-induced TTP remains unknown. However, it is believed to be secondary to formation of anti-platelet factor 4 (PF4) antibodies causing thrombosis in a way similar to, but not related to Heparin‐induced thrombocytopenia (HIT).9 Given the above data, this case is, to our information, the first case of possible vaccine-induced immune TTP through ADAMTS13 autoimmune antibody, following messenger RNA (mRNA)–based vaccines.
Research also argues most drug-induced TMA reports are without concrete evidence and are usually over-reported due to physician bias.10 However, looking at the clinical picture, laboratory values, and exclusion of other possible precipitating causes, all point toward the vaccine to be the culprit. There are limitations in our case; the first is the lack of PLT count recently before the vaccine. This cannot rule out the possibility that our patient was experiencing potential low PLT count and would make a poor candidate for this type of vaccination as per recent studies and vaccine`s manufacturer.2 In addition, Development of TTP after vaccination is infrequent, with < 10 cases reported in the medical literature.7 Also, the SARS-CoV-2 IgG was not tested, and made it possible that undetected post covid infection autoimmunity is behind this condition.5 Regardless of these limitations, this particular case raised the question of the role of vaccine administration due to the temporal relationship of events. Whether the vaccine played a coincidental or a causal role may remain a mystery. Further additional cases and studies are required to reinforce such a critical vaccine-associated adverse condition.
ConclusionUpon review of the literature, this is the first reported case of acquired immune TTP through ADAMTS13 autoimmune antibody, in an HIV patient following COVID 19 messenger RNA (mRNA) vaccination. The current pandemic and the urgent need for mitigation of SARS-COV2 mediated morbidity and mortality resulted in the rapid development of vaccines. The safety and efficacy of current vaccines under us have been extensively reported. This report aims to raise awareness of possible adverse events in special and susceptible populations who may have a different response to vaccines and should be included in the differential diagnosis if the timeline indicates a potential role. Therefore, the dearth of data about adverse events is a sobering concept for the medical research community, and further safety evaluations would give us better guidance.